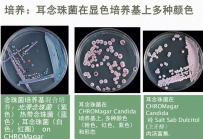
认识耳念株菌，其威胁有哪些，如何进行防控 ？

我院急诊抢救室改造后设置了一个创伤抢救区,配有无影灯,便于第一时间清创、缝合、固定、包扎(一般创面,大面积清创缝合是进手术室处理的),而且这个区域也方便抢救室护士计费、观察,以及用后及时清理 ...
荷儿 |2025-01-26 10:49:49 |10

这是一张换药室的现场照片,请大家来找茬~ 与医务人员或患者应该怎么沟通才有效?
谷子 |2025-01-26 09:25:39 |41

新的一年,重新修订了发热门诊质控督查表,主要是护理部负责督查,想请教大家发热门诊目前含氯消毒剂消毒还需要1000mg/l的浓度吗? 现将质控督查表分享给各位老师,欢迎提出修改意见,我们共同完善 ...
谷子 |2025-01-26 09:15:18 |3

请问各位老师,您医院用于导管接头消毒的酒精棉片是怎么样的呢? 这个酒精棉片的说明书上适用范围是“适用于临床上对完整皮肤消毒使用”,并没有注明可用于导管接头消毒, 请问各位老师您医院用的是哪种 ...
谷子 |2025-01-25 20:07:54 |11
认识耳念珠菌,其威胁有哪些,如何进行防控 ? 收看了2025 年 1 月 16 日直播的《感控S计划》第一季“以案为鉴”第九期,听了专家的精彩讲座和问题解答,对耳念珠菌相关知识有了进一步了解 ...
高山雪莲W |2025-01-26 09:33:43 |8

“规率”行动提高住院患者抗菌药物病原学送检率,这个抗菌药物病原学送检率的目标值是多少?文件里有要求吗?
我想静静 |2025-01-24 11:58:21 |2

在日常工作中,不管是汇报还是做分析报告,我们经常会用到一些多重耐药相关的英文简称,为了方便临床医务人员了解,我将一些常见的多重耐药菌英文简称进行了汇总进行下发,现分享给各论坛老师,如有错误之 ...
花开自有蝴蝶来 |2025-01-24 10:45:31 |8

每一年的岁末,全院感控兼职人员们最期盼的莫过于优秀感控员的评选活动,我院在院领导的大力支持下,连续两年开展了优秀感控员的评选活动,深得临床科室感控兼职人员们的欢喜,1月初下发了评选活动通知, ...
木木叶落87 |2025-01-24 09:19:15 |30
各位老师好!抢救室中心供氧,一次性使用氧气湿化瓶,如何处于备用状态有利于抢救,又符合院感要求?流量表、一次性氧气湿化瓶、吸氧管如何存放?谢谢 ...
月白风清 |2025-01-23 18:53:41 |8

血源性病原体职业接触防护导则 word版(注:就是GBZ/T 213-2008,不是新的)
春语 |2025-01-23 16:50:04 |4